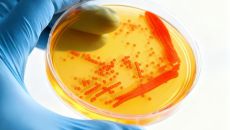

2026
일
월
화
수
목
금
토
-
[기업] 올해 기부 1위 '삼성전자'...증액 1위 'SK하이닉스'
국내 500대 기업 가운데 올해 기부를 가장 많이 한 기업은 삼성전자이고 기부금을 가장 많이 늘린 기업은 SK하이닉스인 것으로 나타났습니다. 기업데이터연- 2025-11-19 13:58
- YTN
-

금호석유화학그룹 임직원, 직접 가꾼 멸종위기종 '파초일엽 '식재
금호석유화학은 최근 멸종위기종 파초일엽의 성공적 양육 및 식재를 진행했다고 19일 밝혔다. 금호석유화학을 비롯한 그룹 6개 회- 2025-11-19 13:58
- 머니투데이
-

김병기 민주당 원내대표, 정치검찰 조작기소대응 특위 전체회의 발언
[이용우 기자] (서울=국제뉴스) 김병기 더불어민주당 원내대표가 19일 서울 여의도 국회에서 열린 정치검찰 조작기소대응 특별위- 2025-11-19 13:58
- 국제뉴스
-

[포토] 경찰, 조사 방해 의혹 KT 판교·방배 사옥 압수수색
경찰이 KT가 무단 소액결제 사건 당시 정부 조사를 방해했다는 의혹 관련해 성남 판교와 서울 방배동에 위치한 KT 사옥 등에- 2025-11-19 13:58
- 전자신문
-
코스맥스, 중국 수련꽃서 항노화 균주 발굴…"마이크로바이옴 독자성 확보"
[서울=뉴스핌] 조민교 기자 = 코스맥스가 중국 천연자원을 기반으로 한 신규 항노화 마이크로바이옴을 발굴하며 소재 연구 경쟁력- 2025-11-19 13:58
- 뉴스핌
-

효성, 29명 임원 인사…배인한·배용배·박남용 부사장 승진
효성그룹은 배인한 동나이법인장, 배용배 중국 남통법인장, 박남용 효성중공업 건설PU장 등 부사장 3명과 신규 임원 13명을 포- 2025-11-19 13:58
- 세계비즈
-

[포토]발표하는 권순일 업스테이지 부사장
[이데일리 이영훈 기자] 권순일 업스테이지 부사장이 19일 서울 중구 더플라자 호텔에서 열린 '이데일리 글로벌 AI포럼(GAI- 2025-11-19 13:58
- 이데일리
-

"네가 왜 여기서 나와" 머스크, 백악관 다시 등장
[이데일리 김겨레 기자] 일론 머스크 테슬라 최고경영자(CEO)가 약 6개월 만에 백악관에 다시 등장했다. 머스크가 도널드 트- 2025-11-19 13:58
- 이데일리
-

이이경 측 "사생활 루머 피해 극심…선처 없이 강경대응" [공식]
[이데일리 스타in 최희재 기자] 배우 이이경이 사생활 루머 유포에 대해 3차 입장을 내고 법적 대응을 재차 강조했다. 이이경- 2025-11-19 13:58
- 이데일리
-

‘J-팝 레전드’ 호시노 겐, 내년 2월 내한 확정…한국 팬과의 약속 지켰다
일본 가수 겸 배우 호시노 겐이 2년 연속 내한 콘서트를 개최한다. 19일 소속사 아뮤즈에 따르면 호시노 겐은 내년 2월 6일- 2025-11-19 13:58
- 스포츠월드
-

배현진 “남욱 부부, 미국서 호화 생활…고급 외제차 돌려타기도”
대장동 개발사업에서 민간업자로 참여한 남욱씨 가족이 범죄수익으로 미국에서 호화 생활을 했다는 주장이 제기됐다. 19일 정치권에- 2025-11-19 13:58
- 매일경제
-

한진, 창립 80주년 맞아 미 재향군인 지원…"베트남전 인연 이어간다"
[서울=뉴스핌] 조민교 기자 = 한진이 창립 80주년을 맞아 80년 전 맺은 역사적 인연을 기리는 상생활동을 이어가며 글로벌- 2025-11-19 13:58
- 뉴스핌
-

두끼, 미국 시장에서 뜨거운 반응…글로벌 외식 브랜드 입지 강화
[최규삼 기자] 【베이비뉴스 최규삼 기자】 두끼가 북미 시장에서 높은 인기를 얻으며 글로벌 브랜드로서의 입지를 더욱 확고히 다- 2025-11-19 13:58
- 베이비뉴스
-

[포토] 국민의힘-대한상의 정책 간담회
최태원(앞줄 왼쪽 네 번째) 대한상공회의소 회장이 19일 서울 중구 대한상의에서 열린 정책 간담회에서 장동혁(앞줄 왼쪽 다섯- 2025-11-19 13:58
- 전자신문
-

인사처, 민간인재 영입지원 통해 경남도 AI 전문가 임용
현대위아 출신 박환 과장 임명 [파이낸셜뉴스] 인공지능·빅데이터 분야에서 제조 혁신을 이끌어온 민간 전문가가 정부의 민간인재- 2025-11-19 13:58
- 파이낸셜뉴스

